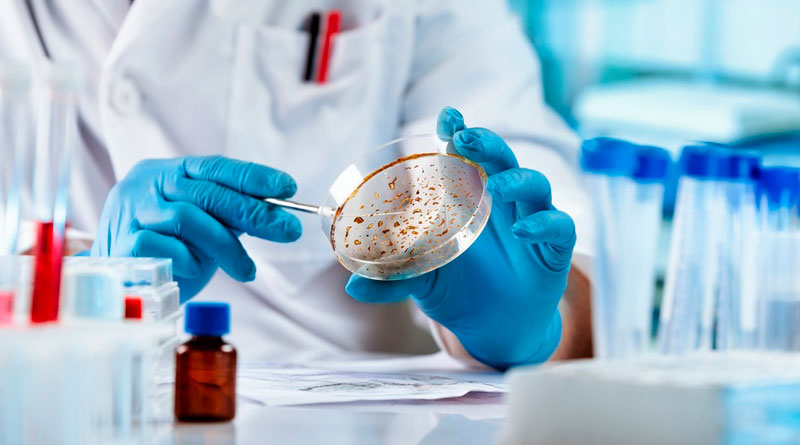

Descubren qué podría causar la hepatitis infantil aguda, registrada en 35 países
La Organización Mundial de la Salud (OMS) ha contabilizado desde el mes de abril 1.010 casos sospechosos en 35 países, incluyendo 22 muertes, y se han practicado 46 trasplantes de hígado.
Un grupo de médicos del Reino Unido reveló que el recién aumento de casos de hepatitis en niños puede ser ocasionado por la presencia de dos agentes infecciosos, el virus adenoasociado 2 (AAV2) y el adenovirus (HAdV), por lo que queda descartada la probabilidad de una infección por SARS-CoV-2, informó la Universidad de Glasgow (Escocia).
De acuerdo con los responsables de la investigación, publicada por el servicio de preimpresión MedRxiv, el pasado mes de abril se detectó en Escocia un brote de hepatitis infantil aguda de origen desconocido. Desde ese momento, la Organización Mundial de la Salud (OMS) ha contabilizado 1.010 casos sospechosos en 35 países, incluyendo 22 muertes, y se han practicado 46 trasplantes de hígado.
La mayoría de los 268 casos reportados en el Reino Unido eran niños menores de cinco años. Asimismo, de los 189 pacientes que fueron hospitalizados, 74 requirieron ser ingresados a la unidad de cuidados intensivos y 12 necesitaron un trasplante de hígado. Los funcionarios de Salud creían anteriormente que el aumento de las infecciones era causado por un adenovirus, ya que fue encontrado en las muestras de niños afectados por la enfermedad hepática.
Ante esta situación, se realizaron dos estudios de manera independiente y simultáneos por investigadores de instituciones científicas de Escocia e Inglaterra con el propósito de encontrar las causas de la infección. El equipo escocés realizó una secuenciación de próxima generación, así como un análisis de reacción de cadena de polimerasa (PCR) en tiempo real. Durante el estudio, descubrieron la presencia del AAV2, que es miembro de la familia de los parvovirus, tanto en la sangre como en el hígado de nueve niños infectados. En el caso del grupo de control, que estuvo integrado por 58 pacientes, no se encontró indicios del AAV2.
Al mismo tiempo, los científicos ingleses estudiaron muestras de hígado y sangre de 28 menores con hepatitis, identificando el AAV2 en 16 de estos. Las muestras fueron comparadas con 132 controles de pacientes inmunocomprometidos (sistema inmunitario bajo) y inmunocompetentes (sistema inmunitario normal). Además, la secuenciación de ARN confirmó que el AAV2 se estaba replicando en el hígado de los pacientes con hepatitis. En ambos estudios se descartó que el SARS-cov-2 sea el responsable de provocar la enfermedad hepática.
Descubriendo como actúa el AAV2
Debido a que el AAV2 no puede replicarse sin un virus «auxiliar», los especialistas determinaron que la aparición de la enfermedad en niños es causada por la existencia de dos virus. En este caso, el AAV2 junto con un adenovirus. En menor frecuencia, el AAV2 puede estar vinculado con el virus del herpes HHV6.
«La presencia del virus AAV2 está asociada con la hepatitis inexplicable en niños», comentó la profesora de la Universidad de Glasgow, Emma Thomson, quien aseguró que «este virus solo puede aparecer con poca frecuencia en presencia de otro virus (generalmente un adenovirus)».
«Hay muchas preguntas sin respuesta y se necesitan con urgencia estudios más amplios para investigar el papel del AAV2 en los casos de hepatitis pediátrica», indicó Thomson, y añadió que es necesario «entender más sobre la circulación estacional del AAV2, un virus que no se controla de forma rutinaria; y puede ser que un pico de infección por adenovirus haya coincidido con un pico en la exposición al AAV2, lo que lleva a una manifestación inusual de hepatitis en niños pequeños susceptibles».
Fuente: RT
